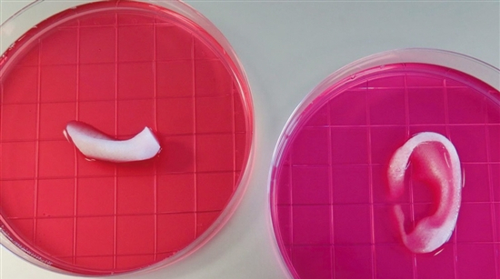

供稿人:李芝 贺健康 发布日期:2018-09-07
随着3D打印技术的发展,人们不再满足于用3D打印技术打印玩具、医用模型、建筑等方面,目前各国的科学家都渴望通过生物3D打印技术人工制造组织、甚至器官,但是这一愿景面临重重困难。但是目前中国科学院的一个团队在三维生物打印制造人工类组织方面取得了新进展。
研究团队通过生物打印优化设计及诱导型生物墨水的研发,构筑了精确排布成骨细胞的“活”类骨组织。制造的“活”人工骨,不仅可以维持细胞短时间的高存活率(24小时内大于95%),并能实现细胞长时间的体内外功能化,促进新骨再生。
将成体细胞或干细胞与生物材料复合作为生物打印墨水,制造具有功能的人工组织与器官是组织修复再生的研究热点和发展趋势。然而,如何维持通过三维打印后活体细胞的短期活性,并实现三维打印人工类组织在体内外的长期功能化,是限制三维生物制造研究应用的瓶颈。阮长顺课题组从事三维生物打印及生物材料墨水的相关研究,先后探索生物材料降解性能调控细胞行为和三维打印构建高强度纳米复合水凝胶的人工骨组织研究。
研究中,科学家团队搭建了一种多通道、常温成型的三维生物制备系统(见图1)。基于该平台,通过材料优化构建,实现用活性的高强度水凝胶/纳米硅镁盐复合生物墨水构建稳固的骨修复支架支撑体系(第一通道)和以生物相容性优异的透明质酸包裹均匀分散的成骨细胞为维持细胞存活体系(第二通道)。两通道交替打印,实现含细胞的“活”人工骨组织(见图2)。前期透明质酸提供细胞保护,维持高细胞存活率和精确排布。后期支撑体系释放骨修复活性离子(镁,硅离子等),促进细胞分化和功能化。

图1 生物3D打印机(左)及生物3D打印的颌骨和耳朵(右)

图2 双通道生物3D打印系统用于生物3D打印的方法
进一步体内动物实验证实,这种“活”类骨组织,不仅具有在骨缺损部位良好的修复能力,还能实现异位新骨生成(见图3)。因此,该研究将推动三维生物制造技术在组织修复再生中的应用。

图3 生物3D打印人工“活”类骨组织示意图及体外、内结果